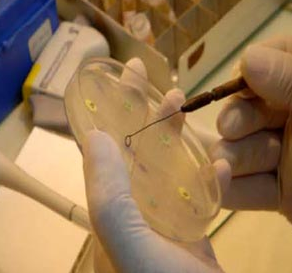

AYAL
CONSULTORÍA DE AGUAS Y CALIDAD, S.C.
PÁGINA PRINCIPAL
(#1) Cumple la Orden SAS/1915/2009 (actualiza el anexo II del RD 140/2003) sobre sustancias empleadas en el tratamiento del agua destinada a consumo humano.
(#2)Los preparados con características biocidas deben ser registrados en Sanidad para su uso en Higiene Alimentaria (código HA).
(#3)Los biocidas antilegionella deben ser registrados en Sanidad para su uso en Torres de Refrigeración.
(#4) Todos los productos de tratamiento de circuitos cerrados son compatibles con glicol y previenen la corrosión generada por este en su degradación.
Cada tipo de producto (cada casilla de la tabla anterior) es una serie de productos con iguales características, en los cuales pueden variar las materias activas y sus concentraciones, dando lugar a un conjunto de preparados químicos "a la carta" según las necesidades puntuales o problemática de la instalación.
Cualquier formulación se aporta con toda la documentación base necesaria, desde el aprovisionamiento de materias primas hasta los controles finales. Esta documentación contiene más de 100 páginas y se compone de los siguientes documentos: Ficha de control materias primas (métodos de ensayo), Ficha de fabricación, Orden de fabricación (con cálculos automáticos en cuanto a cantidades), Intrucción de trabajo, Ficha de control de producto fabricado, Guia de funcionalidad (propiedades de todas las materias primas, sinergia y funcionalidad final del preparado en la instalación), Diseńo del preparado (pruebas de estabilidad y eficacia), Ficha técnica del preparado, Ficha de datos de seguridad, etc. De esta forma todos las formulaciones aportadas llevan consigo de forma inherente toda la documentación soporte para integrarse en un Sistema de Gestión de Calidad ISO 9001, ya existente o por crear.
Todos las formulaciones están probadas en cuanto a estabilidad temporal (mínimo 6 meses desde fecha de fabricación y hasta 24 meses según el preparado) y eficacia sobre la instalación (anticorrosiva y antiincrustante) o biocida sobre la microbiología del agua. Así mismo, el diseńo de cada preparado es específico para cada tipo de instalación sin dar lugar a "efectos secundarios" en la misma, ya que se han previsto todo tipo de situaciones especiales.
AYAL CONSULTORÍA DE AGUAS Y CALIDAD, S.C.
C/ Huesca, 31-33.1şC. 50180 Utebo(Zaragoza)//
625 576 722 - 976 462 903
CALDERAS DE VAPOR
TORRES DE REFRIGERACIÓN Y CONDENSADORES EVAPORATIVOS
CIRCUITOS CERRADOS DE REFRIGERACIÓN (#4)
MEMBRANAS DE OSMOSIS INVERSA
CIRCUITOS / DEPÓSITOS DE AGUA POTABLE Y AGUA CALIENTE SANITARIA
HIGIENE ALIMENTARIA(#2)
Secuestrantes-Dispersantes
Secuestrante-Dispersante-antioxidante
Secuestrantes sin fosfato - dispersante salino-anticongelante- inhibidor de corrosión de accción sinérgica y superficial para cobre, hierro y acero
Inhibidor de incrustación y Dispersante de carbonatos, sulfatos y fosfatos de calcio y magnesio, para cualquier tipo de membrana
Inhibidor de incrustación y corrosión de uso en circuitos de agua fría de consumo humano y agua caliente sanitaria (#1)
Biocidas de desinfección general de superficies y utensilios
Antioxidantes: Eliminadores de oxígeno
Secuestrante-Dispersante-antioxidante-Alcalinizante
Secuestrante sin fosfatos - dispersante salino - dual inhibición anódica sinérgica (cobre, hierro y acero)
Biocida - Limpieza Antifouling y materia orgánica
__________________
Desinfectante- Fungicida
Antioxidantes-antiincrustantes para calderas de alta presión
Secuestrante-Dispersante-antioxidante con estabilizantes de inhibidor de corrosión
Anticongelante - inhibidor de corrosión para Hierro, cobre y acero
Desincrustante de Sulfatos de Bario, Calcio y Magnesio
___________________
Detergente - Biocida - Desincrustante(Carbonato cálcico)
Antioxidantes línea de retorno de condensados
Biocidas antilegionella de distintos principios activos (#3)
Secuestrante sin fosfatos - dispersante salino
Limpieza Antifouling y materia orgánica o coloidal - biocida - Desincrustante carbonatos y óxidos de hierro - dispersante de sulfatos y carbonatos
____________________
Biocida - Detergente - Desincrustante (Sulfatos)